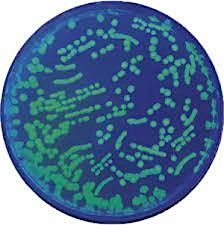

About this Event
Join us for a fun and interactive class where you'll dive into the world of bacterial transformation! We'll explore how scientists can "reprogram" bacteria by giving them new DNA instructions. This process allows bacteria to do amazing things, like producing chemicals, pharmaceuticals, fragrances, and pigments!
Event Venue & Nearby Stays
Baltimore UnderGround Science Space (BUGSS), 101 N Haven St, Baltimore, United States
USD 17.85












